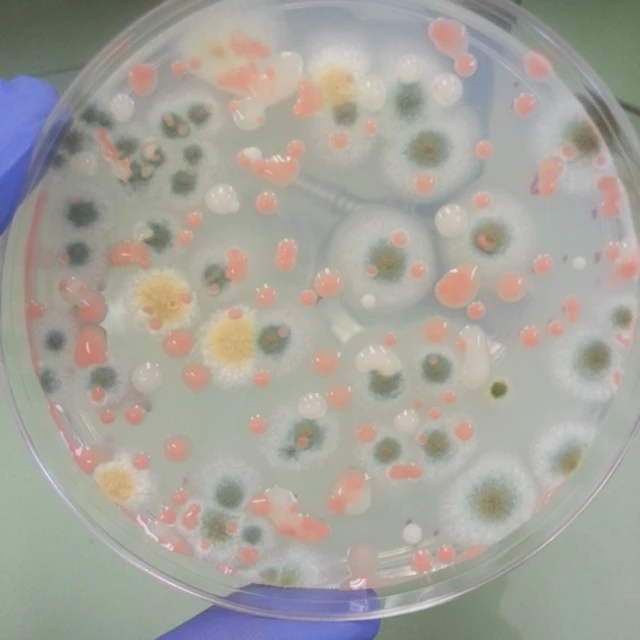
Hongos en un recipiente

Por qué los astronautas pasan horas limpiando las paredes de la Estación Espacial Internacional

Fuente de la imagen, NASA
- Autor, Redacción
- Título del autor, BBC News Mundo
- Tiempo de lectura: 4 min
En algo se parece la Estación Espacial Internacional (EEI) a la mayoría de las casas: las paredes pueden tener moho que es difícil de retirar.
Cada semana los astronautas pasan horas limpiando el interior del complejo orbital para que el moho no genere problemas de salud.
Y un nuevo estudio revela hasta qué punto se trata de una tarea crucial.

Fuente de la imagen, NASA JPL
Las esporas de dos de los hongos más comunes en la EEI, Aspergillus y Pennicillium, sobreviven una exposición de rayos X hasta 200 veces superior a la que mataría a un ser humano, según una investigación de Marta Cortesão, microbióloga del Centro Aerospacial Alemán, DLR por sus siglas en alemán, en la ciudad de Colonia.
Cortesao presentará sus conclusiones ante la Conferencia de Astrobiología que tiene lugar esta semana en Bellevue, en el estado de Washington en Estados Unidos (AbSciCon 2019).
Radiación cósmica
Pennicillium y Aspergillus no suelen ser hongos dañinos para los seres humanos, pero inhalar sus esporas en grandes cantidades puede causar enfermedades en personas con sistemas inmunológicos débiles.
El moho es tan resistente que sobrevive a grandes temperaturas, luz ultravioleta y sequedad extrema.
Fuente de la imagen, NASA JPL

Fuente de la imagen, Science Photo Library
Cortesão simuló la radiación espacial en un laboratorio, donde sometió esporas a un bombardeo de radiación ionizante de rayos X y de un tipo de luz ultravioleta de alta frecuencia que no llega a la Tierra pero está presente en el espacio.
La radiación ionizante mata las células dañando su ADN y otras estructuras celulares esenciales. (Las radiaciones ionizantes son aquellas con energía suficiente para ionizar la materia extrayendo los electrones de sus estados ligados al átomo).
Las esporas sobrevivieron a la exposición a rayos X de hasta 1.000 grays, la exposición a iones pesados 500 grays y la exposición a la luz ultravioleta hasta 3.000 julios por metro cuadrado.
El gray es una medida de la dosis absorbida de radiación ionizante, y se define como la absorción de un julio de energía de radiación por kilogramo de materia.
Una radiación de cinco grays es suficiente para matar a una persona. Y la mitad de un gray es el umbral para enfermedades causadas por radiación.

Fuente de la imagen, NASA
Se espera que un viaje de 180 días a Marte exponga a las naves espaciales y a sus pasajeros a una dosis acumulada de aproximadamente 0,7 grays, por lo que las esporas de Aspergillus sobrevivirían fácilmente a esta radiación cósmica.
El campo magnético de la Tierra protege de alta radiación a naves en la órbita baja terrestre como la Estación Espacial Internacional. Pero esa protección no existe en misiones a la Luna o a Marte.
El pasajero oculto
"Las esporas de estos hongos resisten mucha más radiación de lo que pensábamos, y es preciso tenerlas en cuenta cuando se limpia el interior y el exterior de naves espaciales", señaló Cortesao.

Fuente de la imagen, NASA

Fuente de la imagen, NASA
"Al planificar misiones de larga duración, debemos también tener planes para estas esporas porque es muy probable que sobrevivan el viaje en el espacio".
El estudio también indica que las esporas deben ser incluidas en protocolos que buscan prevenir que naves espaciales contaminen otros planetas o sus satélites con microorganismos terrestres.
Un próximo estudio analizará el impacto combinado en las esporas de la radiación, el frío, el vacío y la baja gravedad en el espacio.
Antibióticos y vitaminas
Cortesao también investiga posibles usos benéficos del moho.

Fuente de la imagen, Science Photo Library
Los hongos podrían ser cultivados en el espacio como fábricas biológicas, ya que las estructuras complejas de sus células podrían servir para elaborar polímeros o producir alimentos.
"El moho no es solo un patógeno o algo que echa a perder la comida", señaló la científica.
"También puede ser usado para producir antibióticos u otros productos útiles para las misiones espaciales de larga duración".

Contenido no disponible
Ver más en FacebookLa BBC no se hace responsable del contenido de sitios externos.Fin del contenido de Facebook

Este artículo contiene contenido proporcionado por Google YouTube. Solicitamos tu permiso antes de que algo se cargue, ya que ese sitio puede estar usando cookies y otras tecnologías. Es posible que quieras leer política de cookies y política de privacidad de Google YouTube antes de aceptar. Para ver este contenido, selecciona 'aceptar y continuar'.
Fin del contenido de YouTube, 2

* La BBC no se hace responsable del contenido de páginas externas.










